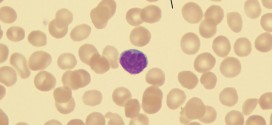

La distrofia miotónica, puede ser la forma adulta más común de distrofia muscular. La miotonía, o la incapacidad de relajar los músculos luego de una contracción súbita, se encuentran solamente en esta forma de distrofia. Las personas con distrofia miotónica pueden vivir una vida larga, con incapacidad variable pero lentamente progresiva. Si no se usa la Trofología, es la única que …
Leer MásEnfermedades
COLITIS ULCEROSA
Se trata de una afectación inflamatoria de tipo crónico del tubo digestivo que evoluciona de modo recurrente con brotes. Resumen: La causa de la colitis ulcerativa se desconoce. A saber. En general es una patología de hoy en día, especialmente debida a los hábitos alimentarios, y todo un sinfín de porquerías que nos metemos en la boca incluyendo los medicamentos. …
Leer MásESFEROCITOSIS
La esferocitosis es una condición que causa una anormalidad en la membrana de glóbulos rojos. Mientras que los glóbulos rojos saludables tienen forma de discos dentados aplanados, estas membranas anormales llevan a glóbulos rojos en forma de esfera, y a la descomposición prematura de esas células. Los glóbulos rojos que sufren de esferocitosis son más pequeños, de forma redonda, y …
Leer MásELIPTOCITOSIS CONGENITA
La eliptocitosis congénita. Es un trastorno que se hereda (congénita) como un rasgo autosómica dominante y que afecta a 1-2 por 4000 ó 5000 habitantes. La forma ovalada se normalmente se adquiere cuando los hematíes se deforman al atravesar la microcirculación y ya no recuperan su forma bicóncava normal o inicial. En la inmensa mayoría de los afectados esto se …
Leer MásBETA-TALASEMIA HOMOCIGOTICA
La beta-talasemia homocigótica. Es una severa anemia microcítica, hipocrómica y hemolítica (que se destruyen los hematíes), que es muy rápidamente progresiva durante el segundo semestre de la vida. Suele falla la síntesis de la cadena beta y de forma bastante característica tiene aumentada la Hb F. Requiere repetidas transfusiones (como objetivo general mantener la Hb por encima de 10g/dl) para …
Leer MásESFEROCITOSIS HEMOLITICA HEREDITARIA (EHH)
La esferocitosis hemolítica hereditaria (EHH) Es una enfermedad que se caracterizada por anemia hemolítica de severidad variable, a saber, con presencia de esferocitos en sangre periférica y una respuesta clínica favorable a la esplenectomía. La esferocitosis hereditaria (EHH), una patología basada en un desorden en la membrana del eritrocito y de herencia autosómica dominante, se manifiesta con presencia de microesferocitos …
Leer MásGlomerulonefritis proliferativa endocapilar
La glomerulonefritis proliferativa endocapilar. Es una lesión que se le conoce también con el nombre de GN proliferativa endocapilar aguda. Se define como una proliferación celular que afecta las áreas mesangiales y las luces capilares. Las células que proliferan son mesangiales, endoteliales y células inflamatorias circulantes que han migrado al penacho. La oclusión de luces capilares se debe en parte …
Leer MásANEMIA HEMOLITICA EXTRACORPUSCULAR
La anemia hemolítica extracorpuscular. La anemia hemolítica de causa extracorpuscular constituye un grupo heterogéneo de entidades, caracterizadas por un acortamiento en la vida media del hematíe por debajo del rango normal de 100-120 días. La causa es siempre adquirida ajena al eritrocito, que presentará características formativas y funcionales rigurosamente normales. El término hemólisis significa reducción de la vida media eritrocitaria, …
Leer MásENFERMEDAD RENAL POLIQUISTICA INFANTIL (ERPI)
La enfermedad renal poliquística infantil (ERPI). Es un trastorno y padecimiento que compromete a ambos riñones en forma simétrica, se trasmite por herencia autosómica recesiva. En General es diagnosticada antes de nacimiento dentro del útero, ocurre como resultado de una mutación genética de los genes PKD, que se encuentra localizado en el cromosoma. A saber. Es una enfermedad poco frecuente, …
Leer MásANEMIA HEMOLITICA ENZIMOPRIVA
Anemia hemolítica enzimopriva o por enzimopatía. Es una variedad de anemia hemolítica hereditaria no esferocitica, de transmisión dominante ligada al sexo. Se caracteriza a la ausencia en los glóbulos rojos de una de las enzimas necesarias para su metabolismo: bien de una enzima del ciclo del glutatión (glucosa – 6 -fosfato-deshidrogenasa o G – 6 – FD especialmente, 6- fosfogluconato-deshidrogenasa …
Leer MásENFERMEDAD DE LANDOUZY-DEJERINE
La enfermedad de landouzy-dejerine. Suele inicialmente afecta músculos de la cara (Facio), hombros (escapulo), y brazos (humera) con debilidad progresiva. Esta forma que es la tercera más común de las distrofias musculares, es un trastorno dominante autosómica. La expectativa de vida es normal, pero algunos individuos se vuelven gravemente discapacitados. Típicamente la evolución de la enfermedad es muy lenta, con …
Leer MásGLOMERULONEFRITIS RAPIDA PROGRESIVA (GNRP)
La glomerulonefritis rápidamente progresiva (GNRP) es un síndrome renal que, si se deja sin tratamiento, rápidamente progresa a una insuficiencia renal aguda y la muerte del individuo en cuestión de meses. En un 50% de los casos, la GNRP se ve asociada con otra enfermedad de base, tal como el síndrome de Goodpasture, el lupus eritematoso sistémico o la granulomatosis …
Leer MásANEMIA HEMOLITICA ENZIMA DEFICIENTE
La anemia hemolítica enzima deficiente. Es la más conocida es la que se origina por una deficiencia de la actividad de la enzima glucosa 6-fosfato deshidrogenasa. Este tipo deficiencia produce un déficit de NADPH, agente reductor generado por el ciclo de las pentosas, que se requiere para mantener el glutatión en estado reducido, mediante la glutatión reductasa. En el eritrocito …
Leer MásDISTROFIA MUSCULAR DEL ANILLO OSEO
La distrofia muscular del anillo óseo. Se refiere a más de una docena de afecciones heredadas caracterizadas por la pérdida progresiva de masa muscular y debilitamiento simétrico de los músculos voluntarios, principalmente los de los hombros y alrededor de las caderas. Se han identificado al menos tres formas de distrofia muscular del anillo óseo dominante autosómica (conocidas como tipo 1) …
Leer MásTALASEMIA MAYOR
La talasemia mayor. Es una severa anemia microcítica, hipocrómica y hemolítica (que se destruyen los hematíes), que es muy rápidamente progresiva durante el segundo semestre de la vida. Suele falla la síntesis de la cadena beta y de forma bastante característica tiene aumentada la Hb F. Requiere repetidas transfusiones (como objetivo general mantener la Hb por encima de 10g/dl) para …
Leer MásENFERMEDAD O SINDROME DE GOODPASTURE
El síndrome o enfermedad de Goodpasture. Otros nombres alternativos. Enfermedad por anticuerpos contra la membrana basal glomerular; Glomerulonefritis rápidamente progresiva con hemorragia pulmonar; Síndrome renal pulmonar; Hemorragia pulmonar por glomerulonefritis. Es una rara enfermedad que puede involucrar insuficiencia renal rápidamente progresiva y enfermedad pulmonar. Es de suma importancia usar la Trofología, para que esto no suceda. Algunas formas de la enfermedad …
Leer MásVIRUS DE LA INMUNODEFICIENCIA HUMANA
El virus de la inmunodeficiencia humana. Para una información completa y su tratamiento ver en: SIDA-VIH Si fuese de su deseo le podemos elaborar un plan trofológico personalizado para usted.
Leer MásANEMIA HEMOLITICA AUTOINMUNE
Las anemias hemolíticas autoinmunes (AHAI) son resultado de la reducción de la vida del eritrocito por mecanismos inmunológicos e incremento de la hemólisis, que en condiciones normales es de 1 %. No siempre se presenta un cuadro anémico, ya que la médula ósea tiene la capacidad de aumentar la producción de eritrocitos logrando compensar la destrucción; el resultado es un …
Leer MásGLOMERULONEFRITIS PROLIFERATIVA EXTRACAPILAR (GNE)
La glomerulonefritis proliferativa extracapilar (GNE) o con semilunas no es una enfermedad específica, sino, una manifestación histológica de daño glomerular severo. El nombre «extracapilar» o GN con «semilunas» (en inglés «crescentic») es utilizado para designar la proliferación celular y/o fibrosa que ocupa el espacio de Bowman, surgiendo desde su cápsula. Extracapilar se refiere a que está por fuera de los …
Leer MásSINDROME CRIOAGLUTININA IDIOPATICO
El síndrome crioaglutinina idiopático. Este síndrome es un tipo de anemia hemolítica autoinmune caracterizada por la presencia de los autoanticuerpos (AAC) fríos (aquellos autoanticuerpos activos a temperaturas por debajo de los 30˚C). La enfermedad de las crioaglutininas representa aproximadamente un 16-32% de la AHAI, cuya tasa anual de incidencia se estima entre el 1/35.000 y 1/80.000 en América del Norte …
Leer Más Binipatia e higienismo Medicina natural alternativa, plantas medicinales y remedios caseros naturales
Binipatia e higienismo Medicina natural alternativa, plantas medicinales y remedios caseros naturales